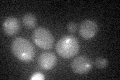
YKL049C
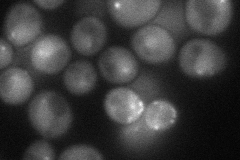
YKL049C
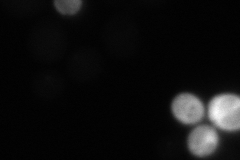
YKL049C
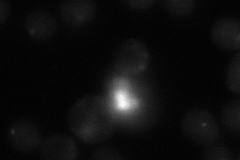
YKL049C

View description
Centromere protein that resembles histone H3, required for proper kinetochore function; homolog of human CENP-A
Localization:
Intensity:
Fold change:
Significance:
-
C’ GFP library in SD
nucleus23.25 -
N' NOP1pr-GFP in SD
cytosol,punctate,nucleus51.3826 -
N' TEF2pr-mCherry in SD
ER12.6431 -
N' NATIVEpr-GFP in SD
punctate33.562 -
N' TEF2pr-VC and Cyto-VN in SD

#N/A0 -
C’ GFP library in SD+DTT

nucleus23.811.02No -
C’ GFP library in SD+H2O2

nucleus28.51.22No -
C’ GFP library in Starvation Media

nucleus17.970.77Yes -
C’ GFP library on the background of Pup2-DaMP

nucleus -
C’ GFP library on the background of CCT mutant

nucleus16.97930.729975No
